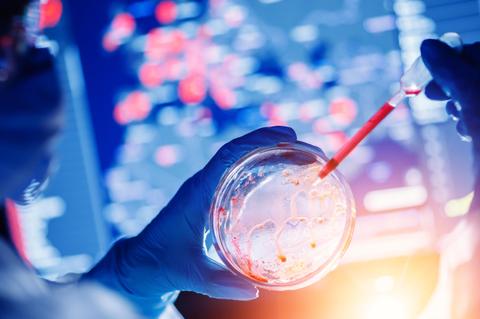
Una mano con guante sostiene un recipiente de laboratorio mientras se agrega un líquido con una pipeta, con un fondo de gráficos y datos científicos.

Zoonosis: Experta explica cómo es posible que un virus pase de un animal a una persona
-La Dra. Vivian D´Afonseca, investigadora del Centro de Investigación de Estudios Avanzados de la UCM, se refirió a varias enfermedades conocidas que provienen de un antecedente de transmisión animal-humano, como ocurrió probablemente en el inicio de la pandemia de SARS-CoV2. “Asociado hay una larga lista de patógenos que van desde bacterias hasta virus que se pueden transmitir a los seres humanos”, indicó.
-La experta UCM, además advirtió sobre la peligrosidad que representan los mercados ilegales para la venta y consumo de animales silvestres, ya que pueden exponer ciertos patógenos con capacidad de infectar a humanos que aún no han sido descritos o todavía no poseen un tratamiento adecuado

Según explicó, en el caso de los virus, las mutaciones suelen estar presentes y suelen ocurrir como resultado de su proceso de replicación, lo que puede generar cambios específicos y puntuales en su secuencia genómica original.
En ese sentido, continuó la experta UCM, es bueno comprender que las mutaciones en los virus pueden surgir como resultado del proceso de replicación de su material genético y pueden estar asociadas con ciertas enzimas que participan en la replicación. “Sin embargo, también pueden surgir por la acción de enzimas presentes en el huésped e incluso, por daño espontáneo a los ácidos nucleicos. Generalmente, los virus de ARN como es el SARS-CoV2 tienden a tener una tasa de mutación más alta que los virus de ADN (…) En el caso de los coronavirus, se observa una menor tasa de mutación y esto probablemente se deba a la acción de una enzima que podría corregir los errores producidos en los procesos de replicación”, señaló la doctora D´Afonseca.
Además, complementó, el tamaño del genoma, el grado de fidelidad de la enzima que corrige los errores posteriores a la replicación, entre otros factores, también pueden influir en la tasa de mutación viral.
“De manera muy general, no todas las mutaciones se establecerán definitivamente en un genoma. Generalmente las mutaciones que confieren una ventaja adaptativa, como el aumento de la transmisión viral o la capacidad de evadir el sistema inmunológico del huésped, pueden aumentar su frecuencia en la población. Cuando esto sucede, es probable que surja una nueva variante o cepa, que se diferencia por la presencia de una o más mutaciones en relación al genoma del virus original”, afirmó la investigadora del CIEAM UCM.
En el caso participar del COVID-19, según D´Afonseca, “Los factores que pueden influir en si una mutación es más peligrosa o no en el contexto actual es cuando le da al virus una nueva capacidad, como ser más contagioso, con una mayor tasa de transmisión, capacidad de evadir el sistema inmunológico del huésped, provocando una condición más grave, además de hacer que las medidas de control disponibles, como la vacunación, sean poco eficaces. Según el CDC (Centro para el Control y la Prevención de Enfermedades), la variante Delta (B.1.617.2), identificada por primera vez en India, es dos veces más contagiosa que otras variantes y puede conducir al desarrollo de una enfermedad más grave, especialmente en personas no vacunadas”, dijo.
“Las variaciones específicas en sitios distintos de una proteína llamada spike, hacen que esta variante tenga una mayor afinidad por unirse a los receptores ACE2 que se encuentran en la superficie de ciertos tipos de células humanas, además de permitir el escape inmunológico en el ambiente celular del huésped, bien cómo incrementar la capacidad de transmisión e infectividad, agregó.
De un animal a una persona
Sobre qué tan común es que un cierto virus que poseen un animal se traspase al ser humano, la doctora D´Afonseca, sostuvo que actualmente existen varias enfermedades conocidas como son leptospirosis, hantavirus, rabia, salmonelosis, entre otras, que provienen de un antecedente de transmisión animal-humano, es decir, son una zoonosis. “Asociado con ellas hay una larga lista de patógenos que van desde bacterias hasta virus. Estos patógenos se pueden transmitir a los seres humanos de diferentes formas, ya sea a través de la práctica agropecuaria, a través de los animales domésticos o provenientes del medio ambiente. Según la Organización Mundial de la Salud (OMS), el contagio puede ocurrir a través del contacto humano directo con agua, medio ambiente o alimentos contaminados”, explicó.
Las zoonosis, detalló la científica de la UCM, “Son un problema de salud pública y forman parte de un plan de la OMS denominado One Health, que tiene como objetivo mitigar los efectos nocivos de estas enfermedades y controlar posibles brotes. Los mercados ilegales para la venta y consumo de animales silvestres son extremadamente dañinos, ya que pueden exponer ciertos patógenos con capacidad de infectar a humanos que aún no han sido descritos o todavía no poseen un tratamiento adecuado. La práctica agropecuaria también puede exponer a los trabajadores a un ambiente con alta contaminación por antibióticos, lo que puede llevar al contacto con patógenos humanos multirresistentes a los antibióticos”, advirtió la doctora D´Afonseca.
Y es que a juicio de la experta UCM, “La alteración del medio ambiente promovida por el hombre también genera un desequilibrio en el hábitat de ciertos animales que puede ser un punto de transmisión de enfermedades entre animales y humanos. El peligro de esto es que cuando un patógeno que se encuentra en su reservorio natural y que puede desarrollar una enfermedad grave, sin tratamiento disponible en humanos, es expuesto al contacto con humanos por los medios mencionados. Una medida muy simple, pero efectiva para evitar las contaminaciones por los patógenos zoonoticos es lavarse siempre las manos al manipular animales y alimentos de origen animal, además de lavar bien frutas, verduras y legumbres antes de su consumo y evitar el consumo de carnes crudas”, acotó.

Sobre la proximidad de las fiestas patrias en Chile y la definición de medidas por parte de la autoridad sanitaria en contexto de pandemia, la experta de la UCM expresó que “Chile se ha destacado por el manejo de la crisis sanitaria y gran parte de este éxito se debe a las normas que se han adoptado como la distancia social, el respeto a los aforos en los lugares públicos, el establecimiento de cuarentenas y el uso obligatorio de mascarillas. Si bien estas medidas no son del todo 100% efectivas, permiten un mejor estudio de cómo progresa la enfermedad”, expuso.
“Asociada a estas medidas está la vacunación, que también consigue contener aún más la aparición de nuevos casos, la aparición de casos graves y también, la muerte. Sin embargo, no hay que descuidarse. El gran aumento de nuevos casos asociados a infecciones por la cepa Delta ya se está observando en algunos países, como Estados Unidos, y debería servir como una advertencia para que Chile tampoco descuide las medidas que venimos adoptando. Por lo tanto, aunque el escenario es favorable en este momento, no sería prudente realizar fiestas públicas con una gran multitud”, puntualizó.
“Mi llamado a la comunidad, más allá de la genética, es como científica y ciudadana. Hago un llamado a todas las personas que forman parte del grupo objetivo de la vacunación y que aún no se han vacunado para que lo hagan. Es muy importante frenar la propagación de la enfermedad y la vacunación disponible es una de las posibilidades para ello. Los estudios confirman que las personas vacunadas tienen un cuadro de infección más corto que las personas no vacunadas y que su carga viral puede ser menor. Además, por más incómodo que parezca, el uso de máscaras y el respeto al aforo de los lugares públicos y / o privados son medidas que salvan vidas. La gestión de la pandemia se ha convertido en un tema del que todos somos responsables y debemos hacer todo lo que esté a nuestro alcance”, cerró D´Afonseca.